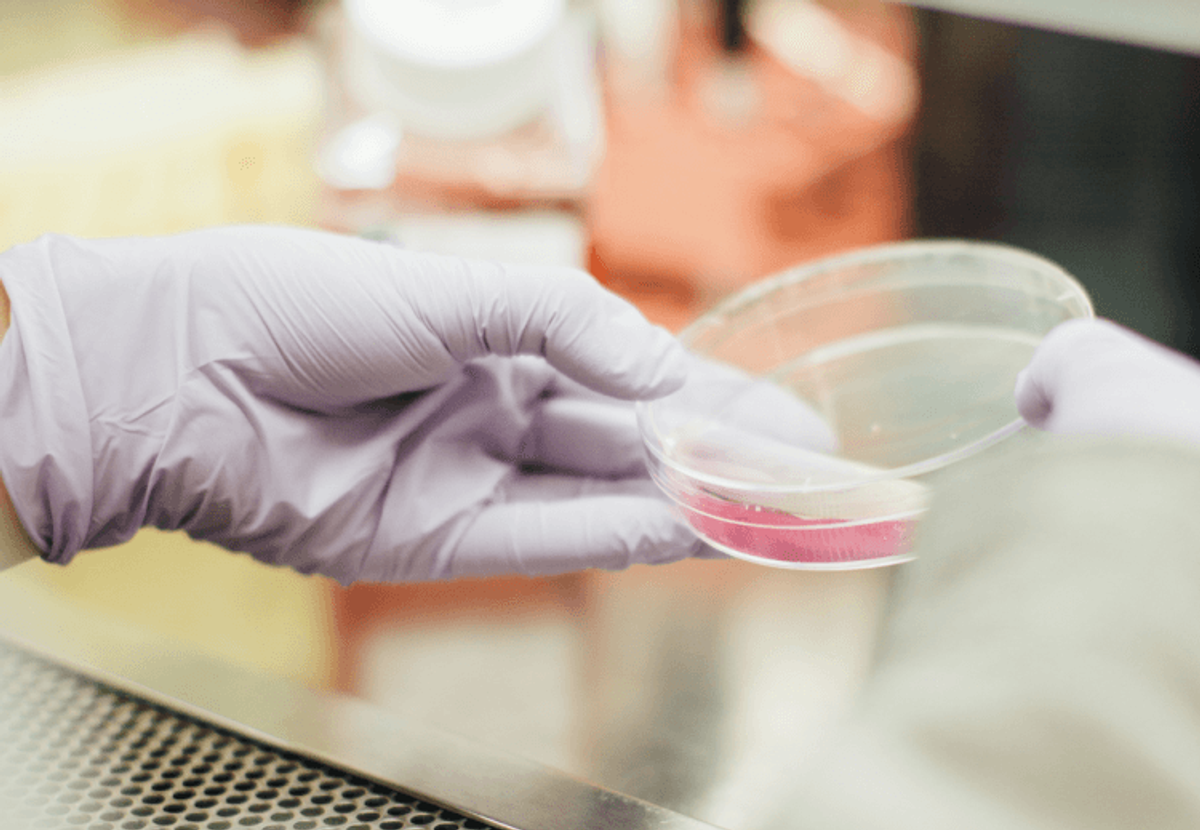

Essential Healthcare Marketing Strategies That Build Patient Trust and Drive Growth
Healthcare organizations face unique challenges when promoting their services while maintaining strict ethical standards and regulatory compliance. Unlike traditional marketing approaches that prioritize sales above all else, healthcare marketing requires a delicate balance between building trust, ensuring patient wellbeing, and adhering to regulations like HIPAA. This specialized field demands strategies that not only increase visibility but also foster genuine connections with patients and healthcare professionals.
Quick Summary
Healthcare marketing requires a careful balance between ethical standards and organizational growth, emphasizing trust and patient wellbeing over mere sales. Strategies intertwining digital techniques such as SEO and social media with traditional outreach help enhance visibility and foster genuine patient relationships. Challenges around compliance with HIPAA and other regulations necessitate transparency and precision in messaging. Successful marketing approaches not only drive patient engagement but also aim to improve health outcomes, achieving a sustainable connection between healthcare organizations and their communities.
Effective healthcare marketing combines digital tactics such as SEO, social media engagement, and targeted email campaigns with traditional community outreach efforts. These approaches help healthcare providers reach prospective patients while building credibility and demonstrating their commitment to quality care. The goal extends beyond simple brand awareness—it's about creating meaningful relationships that improve health outcomes and patient experiences.
Strategic marketing in healthcare has proven essential for organizational growth and patient engagement. When properly executed, these campaigns lower acquisition costs while improving lead quality, ultimately benefiting both healthcare providers and the communities they serve.
Ready to Grow Your Business?
Get a custom strategy tailored to your goals.
Understanding Healthcare Marketing
Healthcare marketing represents a specialized discipline that combines strategic communication with patient-centered care delivery across multiple channels and touchpoints. Organizations operating within the healthcare sector face distinct regulatory requirements and ethical considerations that fundamentally differentiate their marketing approaches from traditional business-to-consumer strategies.
Healthcare marketing encompasses the systematic process of developing targeted communications designed to attract patients, educate communities, and strengthen relationships between healthcare providers and their service populations. This discipline extends beyond simple advertisement placement to include comprehensive patient journey mapping, stakeholder engagement, and outcome measurement across digital and traditional marketing channels.
The regulatory environment surrounding healthcare marketing creates unique constraints that shape every aspect of strategic planning and execution. HIPAA compliance requirements dictate strict protocols for patient data protection, while FDA regulations govern the promotion of medical devices, pharmaceuticals, and treatment methodologies. These regulatory frameworks mandate transparency in messaging, accuracy in health claims, and careful consideration of patient privacy throughout all marketing activities.
Digital transformation has fundamentally altered how healthcare organizations connect with their audiences, creating opportunities for personalized engagement while introducing new compliance challenges. Healthcare marketing strategies now integrate sophisticated data analytics, artificial intelligence-driven personalization, and multichannel distribution systems to deliver targeted messages at optimal moments throughout the patient experience journey.
The Evolution of Healthcare Marketing Practices
Traditional healthcare marketing relied heavily on physician referrals, community reputation, and word-of-mouth recommendations to generate patient volume. However, consumer behavior shifts and increased healthcare transparency requirements have transformed how patients research and select healthcare providers. Modern patients conduct extensive online research before making healthcare decisions, with 84% of healthcare consumers using online resources to evaluate providers and treatment options according to recent industry data.
The emergence of consumer-directed healthcare plans has empowered patients to make more informed decisions about their healthcare spending, creating demand for transparent pricing information and comprehensive service comparisons. Healthcare organizations must now address price transparency requirements while communicating complex value propositions that extend beyond cost considerations to include quality metrics, patient satisfaction scores, and clinical outcomes data.
Social media platforms have introduced new channels for healthcare communication while creating additional compliance considerations around patient privacy and medical advice provision. Healthcare organizations utilize platforms like LinkedIn for professional networking, Facebook for community engagement, and YouTube for educational content distribution, each requiring customized content strategies that align with platform-specific audience expectations and regulatory requirements.
Strategic Foundations of Healthcare Marketing
Effective healthcare marketing strategies begin with comprehensive audience segmentation that extends beyond traditional demographic categories to include health status indicators, care-seeking behaviors, and decision-making patterns. Healthcare organizations must understand the distinct needs of various stakeholder groups, including patients, caregivers, referring physicians, insurance providers, and community leaders, each requiring tailored messaging approaches and communication channels.
Patient persona development in healthcare marketing incorporates clinical factors, psychographic characteristics, and behavioral patterns that influence healthcare decision-making. These personas guide content creation, channel selection, and campaign timing to ensure messages reach the right audiences during optimal moments of receptivity and need.
Brand positioning within healthcare markets requires careful balance between clinical expertise demonstration and approachable patient communication. Healthcare organizations must establish credibility through professional credentials and clinical outcomes while maintaining accessibility and empathy in their messaging tone and visual presentation.
Trust-building remains central to all healthcare marketing activities, as patients make decisions that directly impact their health and well-being based on marketing communications. Healthcare organizations build trust through consistent messaging, transparent communication about services and outcomes, patient testimonial sharing, and community involvement that demonstrates commitment to population health improvement.
Digital Healthcare Marketing Channels
Search engine optimization for healthcare organizations requires specialized knowledge of medical terminology, local search factors, and compliance considerations that affect content creation and website structure. Healthcare SEO strategies focus on creating authoritative content that answers patient questions while adhering to medical accuracy standards and avoiding claims that could be construed as medical advice.
Local search optimization becomes particularly critical for healthcare providers, as 76% of healthcare searches include location-specific terms according to recent search behavior analysis. Healthcare organizations optimize their Google Business Profile listings, maintain accurate directory information across multiple platforms, and create location-specific content that addresses community health needs and concerns.
Content marketing in healthcare involves creating educational resources that inform and engage patients while establishing organizational expertise in specific medical specialties. Healthcare content strategies include blog posts addressing common health concerns, video content explaining procedures and treatments, downloadable resources like health guides and checklists, and interactive tools that help patients assess symptoms or understand treatment options.
Email marketing campaigns for healthcare organizations must balance patient education with appointment reminders, preventive care notifications, and health awareness communications. Successful healthcare email strategies segment audiences based on health interests, appointment history, and engagement patterns to deliver personalized content that drives both patient engagement and clinical outcomes.
Social media marketing for healthcare requires careful content curation that provides value while avoiding medical advice provision. Healthcare organizations use social platforms to share health education content, highlight community involvement, showcase staff expertise, and respond to patient inquiries within appropriate boundaries established by compliance requirements.
Traditional Healthcare Marketing Approaches
Print advertising in healthcare continues to serve specific audiences and geographic markets, particularly for reaching older demographics who prefer traditional media consumption patterns. Healthcare print strategies include medical journal advertisements targeting referring physicians, community publication placements for local market penetration, and direct mail campaigns promoting specific services or health screenings.
Community outreach programs represent a fundamental component of healthcare marketing that builds local relationships while addressing population health needs. Successful outreach initiatives include health fairs, educational seminars, screening programs, and partnerships with local organizations that serve vulnerable populations or address specific health disparities.
Professional referral networks remain critical for specialized healthcare services, requiring targeted marketing approaches that emphasize clinical expertise, collaboration capabilities, and patient outcomes. Healthcare organizations maintain referral relationships through continuing education programs, case consultation availability, and streamlined communication systems that facilitate care coordination.
Radio and television advertising for healthcare services must navigate FCC guidelines while creating compelling messages that drive patient action. Healthcare broadcast strategies typically focus on specific service lines, seasonal health concerns, or crisis response communications that address immediate community health needs.
Measuring Healthcare Marketing Effectiveness
Key performance indicators for healthcare marketing extend beyond traditional marketing metrics to include clinical quality measures, patient satisfaction scores, and health outcome improvements. Healthcare organizations track metrics such as patient acquisition costs, lifetime value calculations, referral source attribution, and appointment completion rates to evaluate marketing program success.
Return on investment calculations in healthcare marketing must account for the long-term nature of patient relationships and the recurring revenue potential associated with chronic disease management and preventive care services. Healthcare ROI analysis includes direct revenue attribution, patient retention metrics, and cross-selling opportunities that result from initial marketing touchpoints.
Patient journey analytics help healthcare organizations understand how marketing touchpoints influence decision-making throughout the care-seeking process. These analytics track interactions from initial awareness through treatment completion and ongoing care relationships, identifying optimization opportunities at each stage of the patient experience.
Quality metrics integration into marketing measurement ensures that patient acquisition strategies align with clinical excellence goals and regulatory requirements. Healthcare organizations monitor quality indicators such as readmission rates, patient safety scores, and clinical outcome measures alongside marketing performance data to ensure sustainable growth that maintains care quality standards.
Compliance and Ethical Considerations
HIPAA regulations significantly impact healthcare marketing activities, requiring careful protocols for patient information use, testimonial collection, and data analytics implementation. Healthcare organizations must establish clear policies for marketing communication review, patient privacy protection, and data security measures that maintain compliance while enabling effective marketing execution.
FDA regulations affect healthcare organizations that promote medical devices, pharmaceuticals, or specific treatment methodologies, requiring substantiation for any clinical claims made in marketing materials. Healthcare marketing teams must understand regulatory boundaries around treatment promotion, outcome claims, and comparative effectiveness statements that could trigger regulatory scrutiny.
Ethical marketing practices in healthcare prioritize patient welfare over revenue generation, ensuring that marketing messages provide accurate information and promote appropriate healthcare utilization. Healthcare organizations establish ethical guidelines for marketing communications that avoid fear-based messaging, exaggerated claims, or pressure tactics that could compromise patient decision-making autonomy.
State and local regulations may impose additional requirements on healthcare marketing activities, including professional advertising standards, patient privacy protections, and specific disclosure requirements for certain types of healthcare services. Healthcare organizations must maintain awareness of regulatory variations across their service areas to ensure comprehensive compliance.
Technology Integration in Healthcare Marketing
Marketing automation platforms designed for healthcare applications include specialized features for compliance management, patient communication scheduling, and clinical data integration that support personalized marketing at scale. These platforms enable healthcare organizations to deliver relevant messages based on patient health status, appointment history, and care plan requirements while maintaining privacy protections.
Customer relationship management systems in healthcare integrate clinical data with marketing communications to support comprehensive patient engagement strategies. Healthcare CRM platforms track patient interactions across multiple touchpoints, enabling care teams to coordinate marketing communications with clinical care delivery for improved patient experiences.
Artificial intelligence applications in healthcare marketing include predictive analytics for patient behavior modeling, natural language processing for content optimization, and chatbot technology for initial patient inquiries. AI-driven healthcare marketing tools must incorporate appropriate safeguards to prevent inappropriate medical advice provision while enhancing patient engagement efficiency.
Telehealth integration with marketing systems enables healthcare organizations to promote virtual care options while streamlining the patient onboarding process for digital health services. Marketing automation can support telehealth adoption through targeted education campaigns, appointment scheduling integration, and technology support resources.
Future Directions in Healthcare Marketing
Personalization technologies continue advancing healthcare marketing capabilities through sophisticated data analysis, behavioral prediction, and dynamic content delivery systems. Healthcare organizations increasingly utilize machine learning algorithms to identify patient needs, predict health service utilization, and customize marketing messages based on individual health profiles and preferences.
Value-based care models are reshaping healthcare marketing strategies to emphasize outcomes, patient satisfaction, and cost-effectiveness rather than volume-based service promotion. Marketing approaches must adapt to support population health management, preventive care promotion, and patient engagement strategies that align with value-based payment structures.
Patient experience optimization through marketing touchpoints creates opportunities for healthcare organizations to differentiate themselves through exceptional service delivery and communication excellence. Marketing strategies increasingly focus on reducing friction in the patient journey, improving access to care, and creating memorable experiences that drive patient loyalty and referral generation.
Data privacy regulations continue evolving, requiring healthcare organizations to adapt their marketing practices to maintain compliance while delivering personalized patient experiences. Healthcare marketers must balance personalization capabilities with privacy protection requirements, implementing transparent data use policies and consent management systems that build patient trust.
Healthcare marketing strategies reflect the unique intersection of business objectives and patient care responsibilities, requiring specialized expertise and careful consideration of regulatory, ethical, and clinical factors that distinguish this field from other marketing disciplines. Organizations that successfully navigate these complexities while delivering value to patients and communities position themselves for sustainable growth and market leadership.
Building Your Healthcare Marketing Foundation

Healthcare organizations require robust foundational elements before launching marketing campaigns. Market analysis, audience segmentation, and measurable objectives form the cornerstone of sustainable healthcare marketing success in 2025.
Conducting Market Analysis and Competitive Research
Market analysis begins with systematically examining healthcare industry trends within your specific service areas. Healthcare organizations must collect data on competitor marketing tactics, patient acquisition strategies, and digital presence effectiveness. This analysis reveals gaps in the market and opportunities for differentiation that drive patient volume growth.
Competitive research encompasses monitoring competitor SEO performance, paid advertising effectiveness, social media engagement rates, and reputation management strategies. Organizations track competitor Google Ads campaigns, organic search rankings, and patient review patterns to identify successful approaches worth adapting. Healthcare providers analyze competitor pricing transparency, service offerings, and patient communication methods to position themselves strategically.
Digital presence evaluation includes examining competitor websites for user experience design, content quality, appointment booking functionality, and mobile responsiveness. Healthcare organizations assess competitor social media strategies across platforms like Facebook, Instagram, and LinkedIn to understand patient engagement patterns and content preferences. This assessment identifies successful content formats such as educational videos, patient testimonials, and health awareness campaigns.
Patient acquisition strategy analysis involves studying competitor referral programs, community outreach initiatives, and partnership networks with other healthcare providers. Organizations examine competitor telehealth offerings, specialty services, and patient portal functionality to identify service gaps they can fill. Market leaders often implement comprehensive digital strategies that smaller practices can adapt to their specific patient populations.
Healthcare consumer behavior trends inform campaign design through analysis of preferred content formats, privacy considerations, and communication channels. Research shows patients increasingly prefer video content for health education, with 73% of healthcare consumers using video content to make healthcare decisions. Understanding these preferences enables organizations to allocate resources toward high-impact marketing channels.
Monitoring competitor pricing strategies reveals market positioning opportunities while maintaining compliance with healthcare regulations. Organizations analyze competitor transparency in pricing, insurance acceptance policies, and payment options to develop attractive patient value propositions. This analysis includes examining competitor patient financing options and membership programs that enhance affordability.
Geographic market analysis identifies underserved patient populations within specific service areas. Healthcare organizations map competitor locations, service availability, and wait times to find opportunities for expansion or improved access. This geographic analysis includes demographic data on population health needs, insurance coverage patterns, and transportation accessibility.
Technology adoption patterns among competitors provide insights into emerging marketing tools and patient engagement platforms. Organizations track competitor implementation of AI-powered chatbots, patient communication systems, and automated appointment scheduling to stay current with patient expectations. Understanding competitor technology investments helps organizations prioritize their own digital infrastructure improvements.
Defining Your Target Audience and Patient Personas
Patient persona development requires comprehensive data analysis combining demographic information, healthcare needs, and digital behavior patterns. Healthcare organizations create detailed profiles representing ideal patients across different service lines and specialties. These personas guide content creation, channel selection, and messaging strategies throughout marketing campaigns.
Demographic segmentation considers age groups, income levels, insurance coverage, geographic location, and family status to identify distinct patient populations. Millennial patients typically prefer digital-first healthcare experiences with easy provider access and mental health support integration. Baby Boomer patients often value personal relationships with healthcare providers and prefer phone-based communication over digital channels.
Healthcare needs segmentation divides patients by medical conditions, preventive care requirements, chronic disease management needs, and treatment urgency levels. Patients with chronic conditions like diabetes require ongoing education content and support resources, while those seeking elective procedures focus on provider credentials and outcome statistics. Emergency care patients prioritize location convenience and wait time information.
Digital comfort levels vary significantly across patient populations and influence marketing channel effectiveness. Patients comfortable with technology engage through patient portals, mobile apps, and social media platforms. Less tech-savvy patients respond better to traditional communication methods like direct mail, print materials, and phone calls from healthcare staff.
Psychographic profiling examines patient values, lifestyle choices, health priorities, and decision-making processes. Health-conscious patients actively seek preventive care information and wellness programs, while others primarily engage healthcare services when experiencing symptoms. Understanding these motivations enables organizations to craft compelling messages that resonate with specific patient mindsets.
Pain point identification reveals common patient frustrations with healthcare experiences such as long wait times, confusing insurance processes, or difficulty accessing specialists. Patients frequently struggle with appointment scheduling, finding in-network providers, and understanding treatment costs. Addressing these pain points in marketing messages demonstrates empathy and positions organizations as patient-focused solutions.
Communication preferences vary by patient demographic and influence marketing channel selection. Research indicates 68% of patients prefer email communication for non-urgent healthcare matters, while 45% prefer text messages for appointment reminders. Understanding these preferences ensures marketing messages reach patients through their preferred channels.
Patient journey mapping identifies touchpoints where patients interact with healthcare organizations from initial awareness through treatment completion and follow-up care. Each touchpoint presents marketing opportunities to provide value, build trust, and enhance patient experience. Mapping reveals gaps where patients might disengage or seek alternative providers.
Specialty-specific persona development recognizes that cardiology patients have different needs and concerns than pediatric patients or mental health patients. Cardiology patients often focus on provider experience and hospital quality ratings, while pediatric patients emphasize convenience and family-friendly environments. Mental health patients prioritize privacy, stigma reduction, and therapy approach compatibility.
Insurance considerations significantly impact patient decision-making and must be incorporated into persona development. Patients with high-deductible health plans prioritize cost transparency and payment flexibility, while those with comprehensive coverage focus more on provider quality and convenience factors.
Setting Measurable Goals and KPIs
Healthcare marketing goals must align with organizational business objectives while reflecting patient-centered outcomes and regulatory compliance requirements. Organizations establish specific, quantifiable targets that drive sustainable growth and improved patient experiences across all service lines.
Patient acquisition metrics measure new patient volume across different service areas and referral sources. Healthcare organizations track new patient appointments, patient demographics, and acquisition costs to optimize marketing spend allocation. Effective patient acquisition strategies generate consistent new patient flow while maintaining healthy margins on marketing investments.
Appointment booking rates indicate marketing campaign effectiveness in converting awareness into actionable patient behavior. Organizations measure online appointment booking completion rates, phone call conversions, and no-show percentages to optimize scheduling processes. Digital appointment booking systems typically achieve 78% higher completion rates compared to phone-based scheduling.
Website engagement metrics provide insights into patient information-seeking behavior and content effectiveness. Healthcare organizations track page views, time on site, bounce rates, and conversion rates for specific landing pages. High-performing healthcare websites achieve average session durations exceeding 3.5 minutes with bounce rates below 55%.
Lead quality assessment measures the alignment between marketing-generated leads and ideal patient profiles. Organizations evaluate lead demographics, insurance coverage, and service needs to ensure marketing efforts attract target patient populations. Quality leads convert to appointments at rates 40% higher than unqualified leads.
Return on investment calculations demonstrate marketing campaign financial effectiveness and guide future budget allocation decisions. Healthcare organizations measure marketing spend against patient lifetime value, considering factors like repeat visits, referrals, and service utilization patterns. Successful healthcare marketing campaigns typically generate ROI ratios between 3:1 and 5:1.
Patient satisfaction scores reflect marketing message accuracy and expectation management effectiveness. Organizations track patient experience ratings, Net Promoter Scores, and complaint resolution rates to ensure marketing promises align with actual service delivery. High patient satisfaction scores correlate with increased referral rates and positive online reviews.
Digital channel performance metrics evaluate effectiveness across different marketing platforms and content types. Healthcare organizations measure email open rates, social media engagement, search engine rankings, and paid advertising click-through rates. Email marketing in healthcare typically achieves open rates around 25% with click-through rates near 4.2%.
Conversion funnel analysis identifies drop-off points in the patient journey from initial awareness to treatment completion. Organizations track progression rates through awareness, consideration, appointment booking, and treatment phases to optimize patient experience at each stage. Effective conversion optimization can improve overall patient acquisition rates by 20-30%.
Brand awareness measurement assesses marketing impact on organizational visibility and reputation within target markets. Healthcare organizations conduct periodic surveys measuring assisted and unaided brand recognition, brand preference, and brand association with quality healthcare services. Strong brand awareness correlates with increased patient inquiries and referral rates.
Compliance tracking ensures marketing activities meet healthcare regulatory requirements while achieving business objectives. Organizations monitor HIPAA compliance in patient communications, advertising claim accuracy, and consent management for marketing activities. Compliance violations can result in significant financial penalties and reputation damage.
AI-powered analytics tools enhance KPI tracking accuracy and enable real-time campaign optimization. Healthcare organizations use machine learning algorithms to analyze patient behavior patterns, predict conversion likelihood, and personalize marketing messages. Advanced analytics capabilities improve marketing effectiveness while reducing manual reporting requirements.
Long-term patient retention metrics measure marketing effectiveness in building lasting healthcare relationships beyond initial acquisition. Organizations track patient loyalty scores, repeat visit frequencies, and service line cross-utilization to evaluate sustainable growth potential. Strong patient retention reduces acquisition costs and increases lifetime value calculations.
Essential Digital Marketing Strategies

Healthcare organizations increasingly rely on sophisticated digital marketing approaches to connect with patients and healthcare professionals. These strategies emphasize AI-driven personalization, mobile-first design, and strict regulatory compliance to build trust while driving meaningful engagement.
Search Engine Optimization for Healthcare
Search engine optimization forms the cornerstone of healthcare digital marketing, with 44% of Internet users actively searching online for doctors and other health professionals. Healthcare organizations must implement comprehensive SEO strategies that combine technical optimization with patient-focused content to capture this substantial search traffic.
AI and predictive analytics now drive modern healthcare SEO initiatives, enabling organizations to optimize website content based on real-time search patterns and patient behavior data. These technologies analyze patient demographics, preferences, and search queries to create targeted content that addresses specific health concerns and medical conditions.
Healthcare SEO requires extensive keyword research focusing on medical terminology, condition-specific queries, and local search terms. Organizations target long-tail keywords such as "pediatric cardiologist near me" or "diabetes management specialist" to capture patients with specific healthcare needs. This approach generates higher conversion rates compared to broad medical terms that attract general information seekers.
Technical SEO elements prove particularly crucial for healthcare websites. Page loading speed directly impacts patient experience, with studies showing that 53% of mobile users abandon sites taking longer than three seconds to load. Healthcare organizations prioritize mobile optimization since patients increasingly use smartphones to research symptoms, find providers, and schedule appointments.
Local SEO strategies help healthcare providers dominate geographic search results. Google Business Profile optimization includes accurate business hours, contact information, accepted insurance plans, and telehealth service availability. Healthcare organizations that maintain complete, updated profiles receive 70% more location visits compared to incomplete listings.
Content authority building represents another critical SEO component for healthcare organizations. Search engines prioritize websites demonstrating expertise, authoritativeness, and trustworthiness (E-A-T) when ranking health-related content. Healthcare providers achieve this by publishing medically accurate content authored by licensed professionals, obtaining relevant medical certifications, and maintaining updated physician credentials.
Schema markup implementation helps search engines understand healthcare content structure, improving visibility for appointment booking features, physician information, and service descriptions. Healthcare organizations using structured data see average click-through rate improvements of 30% for relevant medical searches.
Regular SEO audits ensure healthcare websites maintain optimal performance while adapting to search engine algorithm updates. Organizations track organic traffic growth, keyword ranking improvements, and conversion rates from organic search to measure SEO effectiveness and adjust strategies accordingly.
Pay-Per-Click Advertising and Paid Search
Pay-per-click advertising enables healthcare organizations to reach qualified patients immediately when they search for medical services. PPC campaigns deliver targeted messaging to patients ready to receive care, making them essential for organizations seeking immediate visibility and patient acquisition.
Healthcare PPC strategies utilize first-party data to create precise audience segments targeting specific patient demographics, medical conditions, and geographic locations. Advanced targeting options include age ranges for age-specific procedures, income levels for elective treatments, and behavioral patterns indicating healthcare service interest.
AI-powered PPC optimization tools analyze campaign performance data to automatically adjust bidding strategies, ad copy, and targeting parameters. These systems identify high-converting keywords, optimal ad placement times, and audience segments most likely to book appointments or request information.
Healthcare organizations face unique PPC challenges related to HIPAA compliance and advertising restrictions. Google Ads policies prohibit certain medical claims and require healthcare advertisers to verify credentials before promoting prescription medications or medical devices. Successful campaigns focus on general health education and service availability rather than specific treatment outcomes.
Location-based PPC targeting proves particularly effective for healthcare providers serving specific geographic areas. Campaigns targeting users within defined radius distances from healthcare facilities generate higher conversion rates while reducing advertising costs by eliminating irrelevant traffic from distant locations.
Ad copy optimization requires careful balance between compelling messaging and regulatory compliance. Successful healthcare PPC ads emphasize credentials, insurance acceptance, appointment availability, and patient convenience factors without making unsubstantiated medical claims or promising specific treatment results.
Remarketing campaigns re-engage website visitors who viewed specific services but didn't schedule appointments. Healthcare organizations create targeted ads for users who researched particular procedures, viewed physician profiles, or started but didn't complete appointment booking processes.
PPC campaign performance tracking extends beyond standard metrics to include appointment booking rates, patient acquisition costs, and lifetime patient value. Healthcare organizations achieving optimal PPC results typically see cost-per-acquisition rates 40% lower than industry averages through strategic campaign optimization and audience targeting.
Budget allocation strategies distribute PPC spending across high-intent keywords, seasonal health concerns, and emergency service promotions. Organizations adjust bidding strategies based on appointment availability, staff scheduling, and capacity management to ensure advertising investments align with service delivery capabilities.
Content Marketing and Educational Resources
Content marketing establishes healthcare organizations as trusted information sources while addressing patient concerns and educational needs. Modern healthcare content strategies incorporate diverse formats including podcasts, video storytelling, augmented reality experiences, and interactive webinars to engage different learning preferences.
Educational content creation focuses on patient pain points, digital health literacy improvement, and recent medical advancement explanations. Healthcare organizations develop content libraries addressing common conditions, treatment options, prevention strategies, and wellness maintenance tips using language accessible to diverse patient populations.
Video content performs exceptionally well for healthcare marketing, with medical educational videos receiving 3x higher engagement rates compared to text-based content. Healthcare providers create procedure explanation videos, physician introduction segments, patient testimonial stories, and virtual facility tours to build familiarity and reduce appointment anxiety.
Podcast development allows healthcare organizations to reach patients during commute times and daily activities. Medical podcasts covering health tips, expert interviews, and condition-specific discussions build audience loyalty while establishing physicians as thought leaders in their specialties.
Interactive content formats such as symptom checkers, health risk assessments, and treatment decision tools provide immediate value while capturing patient contact information for follow-up marketing. These tools generate 2x higher conversion rates compared to static educational content.
Content personalization uses patient data insights to deliver relevant health information based on age, gender, medical history, and expressed interests. Personalized content campaigns show 19% higher engagement rates and 27% more appointment bookings compared to general health content distribution.
Healthcare organizations develop content calendars aligned with seasonal health concerns, awareness months, and community health events. Flu season content, heart health awareness materials, and preventive screening reminders reach patients when health topics are most relevant to their immediate needs.
Patient-generated content including testimonials, recovery stories, and treatment experience reviews builds authentic connections with prospective patients. Healthcare providers carefully manage patient privacy while showcasing positive outcomes and community impact stories.
Content distribution strategies utilize multiple channels including website blogs, social media platforms, email newsletters, and patient portal communications. Multi-channel distribution increases content reach by 78% compared to single-platform publishing approaches.
Compliance considerations ensure all educational content meets medical accuracy standards while avoiding specific treatment recommendations that require individual medical consultation. Healthcare content teams include licensed medical professionals who review materials for clinical accuracy and regulatory compliance.
Content performance measurement tracks engagement metrics, educational goal achievement, and patient behavior changes resulting from information consumption. Healthcare organizations monitor content effectiveness through website analytics, social media engagement, patient feedback, and subsequent appointment booking patterns.
Reputation Management and Patient Engagement

Healthcare organizations recognize that digital reputation directly impacts patient acquisition and retention decisions. Effective reputation management strategies integrate patient feedback systems across multiple platforms while maintaining engagement through proactive communication channels.
Online Reviews and Reputation Building
Healthcare providers face intense scrutiny from patients who increasingly rely on digital reviews to make medical decisions. Research indicates that 84% of patients consider online reviews important when selecting healthcare providers, while 77% use online reviews as their first step in finding new doctors. Patients consistently avoid providers with ratings below four stars, regardless of referral sources or insurance networks.
Building a strong online reputation requires systematic monitoring across review platforms including Google Business, Healthgrades, Vitals, and specialized medical directories. Healthcare organizations must track mentions on social media platforms, healthcare forums, and patient advocacy websites to maintain comprehensive oversight of their digital presence. Advanced reputation management platforms aggregate feedback from multiple sources, providing real-time alerts when new reviews appear.
Encouraging positive reviews demands strategic timing and appropriate communication methods that comply with HIPAA regulations. Healthcare providers who send follow-up surveys within 24-48 hours after appointments see 40% higher response rates compared to those who wait longer periods. Text message reminders achieve 23% higher engagement rates than email requests for patient feedback.
Responding to negative reviews presents unique challenges for healthcare organizations due to patient privacy constraints. Providers must craft responses that acknowledge concerns without revealing protected health information or discussing specific treatment details. Professional response templates should express empathy, offer offline resolution pathways, and demonstrate commitment to patient satisfaction while maintaining regulatory compliance.
Star ratings significantly impact search engine visibility and patient conversion rates. Healthcare providers with 4.5-star average ratings receive 300% more website traffic than those with 3-star ratings. Google's algorithm prioritizes businesses with higher review volumes and better ratings in local search results, making reputation management essential for digital marketing success.
Healthcare organizations implementing structured review management programs report 65% increases in positive feedback within six months. These programs typically include automated review invitations, staff training on patient experience protocols, and systematic processes for addressing service issues before they generate negative reviews.
Patient testimonials serve different purposes than standard reviews, offering detailed narratives about treatment experiences and outcomes. Video testimonials generate 80% more engagement than written reviews, providing authentic patient voices that resonate with prospective patients. Healthcare providers must obtain proper consent and releases before using patient stories in marketing materials, ensuring compliance with privacy regulations.
Ready to Grow Your Business?
Get a custom strategy tailored to your goals.
Managing online reputation extends beyond responding to reviews to include proactive content creation that showcases expertise and patient care quality. Healthcare providers who regularly publish patient success stories, educational content, and behind-the-scenes glimpses of their practice build stronger emotional connections with their audience. This content strategy helps balance negative feedback with positive brand messaging across digital platforms.
Patient Referral Programs
Patient referral programs transform satisfied patients into active advocates for healthcare organizations through structured incentive systems. These programs leverage the inherent trust between patients and their social networks to generate qualified leads with higher conversion rates than traditional advertising methods.
Successful referral programs typically offer dual incentives, rewarding both referring patients and new patients who join the practice. Common incentives include service discounts, priority scheduling, wellness products, or credits toward future treatments. Healthcare organizations must carefully structure these incentives to comply with Anti-Kickback Statute regulations and state-specific healthcare marketing laws.
Digital referral tracking systems enable healthcare providers to monitor program performance and automate reward distribution. Modern platforms integrate with electronic health records and practice management systems, automatically identifying eligible referrals and triggering reward fulfillment processes. These systems track referral sources, conversion rates, and lifetime patient value to calculate program ROI.
Word-of-mouth marketing proves particularly effective in healthcare settings because medical decisions carry significant emotional weight and financial implications. Patients typically consult trusted friends, family members, and colleagues before selecting healthcare providers, making personal recommendations extremely valuable. Studies show that referred patients demonstrate 37% higher retention rates and 25% greater lifetime value compared to patients acquired through other marketing channels.
Healthcare specialties requiring ongoing relationships, such as primary care, dermatology, and mental health services, benefit most from referral programs due to higher patient lifetime values. Specialty practices often see 15-20% of new patients arriving through referral programs within 12 months of program launch.
Referral program communication must balance enthusiasm with professionalism while avoiding any appearance of commercializing healthcare relationships. Marketing materials should emphasize the program's intent to help patients access quality care rather than focusing solely on rewards. Healthcare providers who frame referral programs as community health initiatives see better patient participation rates and fewer regulatory concerns.
Timing referral program invitations requires careful consideration of patient satisfaction levels and treatment outcomes. Healthcare organizations typically achieve best results by requesting referrals 30-60 days after successful treatment completion, allowing sufficient time for patients to experience positive outcomes and feel confident recommending the provider.
Medical ethics considerations require healthcare providers to ensure referral programs don't influence clinical decision-making or create conflicts of interest. Clear program guidelines should specify that referrals must be based on patient satisfaction and clinical appropriateness rather than financial incentives. Staff training programs help ensure consistent program implementation that maintains professional standards.
Measuring referral program success extends beyond counting new patient acquisitions to include tracking referral quality, patient satisfaction scores, and long-term retention rates. Healthcare organizations with successful programs typically see 25-30% of new patients arriving through referrals within two years of program implementation.
Social Media Marketing for Healthcare
Social media platforms provide healthcare organizations with direct communication channels to engage patients, share educational content, and build brand recognition across diverse demographic groups. Healthcare social media marketing requires specialized strategies that balance patient engagement with strict regulatory compliance requirements.
Facebook remains the primary social media platform for healthcare marketing, with 89% of healthcare organizations maintaining active business pages. Facebook's business tools enable healthcare providers to share educational content, patient testimonials, staff introductions, and community health initiatives while maintaining professional boundaries. The platform's event promotion features help healthcare organizations advertise health screenings, educational seminars, and wellness programs to targeted local audiences.
LinkedIn serves different purposes for healthcare marketing, focusing on professional networking, thought leadership content, and physician recruitment rather than direct patient engagement. Healthcare executives and medical professionals use LinkedIn to share industry insights, research findings, and policy discussions that establish organizational expertise within professional healthcare communities.
Instagram's visual format suits healthcare organizations that want to showcase facilities, introduce staff members, and share behind-the-scenes glimpses of daily operations. Healthcare providers use Instagram Stories to share real-time updates, patient education tips, and wellness challenges that encourage follower engagement. The platform's hashtag functionality helps healthcare content reach patients searching for specific health topics or local medical services.
YouTube enables healthcare organizations to create comprehensive educational content libraries that address common patient questions and concerns. Medical professionals who regularly publish educational videos build personal brands that enhance their organizations' reputations. Healthcare YouTube channels focusing on patient education see average engagement rates 40% higher than promotional content channels.
Social media content calendars help healthcare organizations maintain consistent posting schedules while ensuring content variety across educational, promotional, and community engagement categories. Successful healthcare social media strategies typically allocate 60% of content to patient education, 25% to organizational updates, and 15% to promotional messaging about services or achievements.
Patient privacy considerations require healthcare organizations to obtain explicit consent before featuring patients in social media content. HIPAA compliance extends to social media interactions, requiring healthcare providers to avoid discussing specific patient cases or responding to medical questions through public social media channels. Private messaging features should redirect patients to appropriate clinical communication channels.
Social media advertising enables healthcare organizations to target specific demographics, geographic locations, and health interests while adhering to platform-specific healthcare advertising policies. Facebook and Google advertising platforms have implemented specialized approval processes for healthcare advertisers, requiring additional documentation and compliance verification.
Crisis management protocols become essential for healthcare social media marketing due to the sensitive nature of medical topics and potential for negative feedback. Healthcare organizations must prepare rapid response strategies for addressing patient complaints, medical misinformation, or regulatory violations that appear on social media platforms.
Influencer partnerships in healthcare require careful vetting to ensure collaborators maintain appropriate credentials and ethical standards. Healthcare organizations working with patient advocates, wellness influencers, or medical professionals must verify their qualifications and ensure promotional content complies with FDA guidelines and professional medical standards.
Social media analytics help healthcare organizations track engagement metrics, audience growth, and content performance across platforms. Key performance indicators for healthcare social media include follower growth rates, engagement percentages, website traffic from social channels, and appointment bookings attributed to social media campaigns.
Community building through social media enables healthcare organizations to create supportive environments for patients managing chronic conditions or recovering from major procedures. Private Facebook groups and LinkedIn communities provide spaces for patient education, peer support, and ongoing engagement that extends beyond clinical appointments.
Social media customer service requires dedicated staff training and clear protocols for handling patient inquiries, appointment requests, and complaints through social platforms. Healthcare organizations must establish boundaries between social media interactions and clinical communications while maintaining responsive, helpful customer service standards.
Healthcare organizations using AI-powered social media tools can personalize content delivery and optimize posting schedules based on audience engagement patterns. These tools help healthcare marketers create more targeted content strategies while maintaining compliance with healthcare regulations and platform policies.
Advanced Healthcare Marketing Techniques
Healthcare organizations recognize that sophisticated marketing approaches drive patient engagement and organizational growth in measurable ways. AI integration optimizes personalized patient journeys and enhances website content through predictive analytics, while automated chatbots streamline communication and appointment scheduling processes.
Email Marketing and Patient Communication
Email marketing campaigns that comply with HIPAA regulations create personalized communication pathways between healthcare providers and patients. Automated email sequences nurture patient relationships through timely, relevant messaging that improves appointment attendance rates by up to 32% and increases patient retention across multiple touchpoints.
Healthcare organizations segment email audiences based on demographics, behavioral patterns, and technology comfort levels to deliver targeted content. Patients aged 65 and older respond favorably to simplified email designs with larger fonts and clear call-to-action buttons, while younger demographics engage more with interactive content and mobile-optimized formats. This segmentation approach increases email open rates by 15-25% compared to generic messaging strategies.
Personalized email communication addresses specific patient needs through tailored content delivery. Appointment reminders sent 48 hours before scheduled visits reduce no-show rates by 18%, while follow-up emails containing care instructions improve medication adherence by 23%. Healthcare providers use patient data to customize email content based on treatment history, upcoming procedures, and preventive care recommendations.
Automated email workflows guide patients through various healthcare journeys, from initial consultation to post-treatment follow-up. Pre-appointment emails containing necessary forms and preparation instructions reduce check-in time by an average of 8 minutes per patient. Post-visit surveys delivered via email generate response rates of 34%, providing valuable feedback for service improvement initiatives.
HIPAA compliance requirements shape email marketing strategies through secure communication protocols. Healthcare organizations implement encrypted email systems and obtain explicit patient consent before sending marketing communications. Patient data protection measures include secure server storage, limited access controls, and regular security audits to maintain regulatory compliance.
Email marketing analytics track patient engagement metrics beyond traditional open and click rates. Healthcare providers monitor appointment booking conversions, patient portal registrations, and educational content consumption to measure campaign effectiveness. These metrics inform iterative improvements to email content, timing, and frequency strategies.
Healthcare email campaigns focus on patient education through condition-specific content and treatment information. Monthly newsletters containing health tips, seasonal wellness advice, and preventive care reminders maintain ongoing patient engagement. Educational email series addressing chronic disease management achieve 67% completion rates when delivered in digestible, weekly installments.
Email automation extends to prescription refill reminders, wellness check notifications, and preventive screening alerts. These automated communications reduce administrative burden while improving patient health outcomes through consistent care coordination. Healthcare organizations report 28% increases in preventive screening participation when patients receive targeted email reminders.
Video Marketing and Patient Testimonials
Video content serves as a preferred medium for healthcare education and patient engagement, with 73% of patients reporting improved understanding of medical conditions through video explanations. Healthcare organizations use video marketing to convey complex medical information in accessible formats that patients retain more effectively than text-based materials.
Patient testimonial videos create emotional connections that influence healthcare decision-making processes. Authentic patient stories highlighting treatment experiences and outcomes build trust and credibility for healthcare providers. These testimonials address common patient concerns and demonstrate real-world treatment results, making them particularly effective for specialty medical services and elective procedures.
Educational video content covers treatment explanations, procedure preparations, and post-care instructions. Healthcare providers create video libraries addressing frequently asked questions, reducing phone inquiries by up to 40% while empowering patients with readily accessible information. Surgical explanation videos help patients understand procedures, reducing pre-operative anxiety and improving informed consent processes.
Video testimonials featuring diverse patient demographics expand reach and relatability across different audience segments. Healthcare organizations carefully select testimonial participants to represent various age groups, medical conditions, and cultural backgrounds. These diverse testimonials resonate with broader patient populations and address specific concerns within different communities.
Behind-the-scenes video content humanizes healthcare providers and facilities. Virtual facility tours, physician introductions, and staff spotlights create familiarity and comfort for prospective patients. These videos reduce anxiety associated with new patient visits and help establish personal connections before initial appointments.
Live streaming capabilities enable real-time patient education and Q&A sessions. Healthcare providers host monthly live streams addressing seasonal health topics, answering patient questions, and providing health updates. These interactive sessions generate average viewership of 150-300 participants and create ongoing engagement opportunities.
Video marketing metrics track patient engagement and content effectiveness through watch time, completion rates, and conversion tracking. Healthcare organizations monitor video performance across multiple platforms including websites, social media channels, and patient portals. Video content with clear calls-to-action generates appointment requests at rates 5 times higher than static content.
Professional video production ensures high-quality content that reflects healthcare organization standards. Healthcare providers invest in proper lighting, sound equipment, and editing software to create polished videos that maintain credibility. Well-produced testimonial videos achieve 89% higher engagement rates compared to amateur productions.
Video accessibility features including closed captions and audio descriptions expand content reach to patients with hearing or visual impairments. These accessibility measures comply with ADA requirements while demonstrating healthcare organizations' commitment to inclusive patient care. Captioned videos also improve engagement among patients who prefer silent viewing in waiting areas.
Local Marketing and Community Outreach
Local search engine optimization strategies connect patients with nearby healthcare providers through location-based content and optimized Google Business Profiles. Healthcare organizations with complete, accurate local listings receive 47% more website visits and generate 32% more phone inquiries than those with incomplete profiles.
Community outreach programs build brand awareness through health fairs, wellness events, and educational workshops. Healthcare organizations report increased patient acquisition rates of 23% following sustained community engagement initiatives. These events provide opportunities for direct patient interaction while demonstrating healthcare expertise within local communities.
Google Business Profile optimization enhances local search visibility through accurate information, regular updates, and patient review management. Healthcare providers maintain current hours, services, and contact information while responding to patient reviews professionally. Optimized profiles with recent patient reviews rank higher in local search results, increasing visibility for location-based searches.
Partnership development with local businesses, schools, and community organizations expands healthcare marketing reach. Workplace wellness programs offered by healthcare providers generate employee participation rates of 68% and create referral opportunities for family members. These partnerships establish healthcare organizations as community health resources while building professional networks.
Community health screenings and free consultation events attract new patients while demonstrating commitment to public health. Healthcare organizations offering blood pressure screenings, cholesterol tests, or diabetes education report converting 34% of screening participants into regular patients within six months. These events create positive community associations while identifying patients needing ongoing care.
Local content marketing addresses community-specific health concerns and seasonal health issues. Blog posts about regional allergens, local fitness opportunities, and community health statistics improve search engine rankings for location-based queries. This localized content approach generates 42% higher engagement rates compared to generic health information.
Physician and staff engagement on professional and personal digital channels expands referral networks within local communities. Healthcare providers encourage staff participation in community events, professional associations, and local social media groups. This grassroots engagement approach builds personal relationships that translate into professional referrals.
Local media partnerships create publicity opportunities through health expert interviews, seasonal health tips, and community health initiatives. Healthcare organizations establishing regular media relationships receive an average of 12 media mentions annually, generating estimated publicity value of $45,000 per year. These media appearances position healthcare providers as local health authorities.
Community event sponsorship increases brand visibility while supporting local causes. Healthcare organizations sponsoring youth sports teams, charity runs, or community festivals report brand recognition improvements of 38% within their service areas. Strategic sponsorship selection aligns with target patient demographics and organizational values.
Influencer partnerships with local fitness instructors, nutritionists, and wellness coaches extend healthcare marketing reach through trusted community voices. Micro-influencers with 1,000-10,000 local followers generate higher engagement rates than larger influencers, making them effective partners for healthcare marketing initiatives. These partnerships create authentic endorsements that resonate with local audiences.
Healthcare organizations measure local marketing effectiveness through appointment attribution, referral source tracking, and geographic patient data analysis. Community outreach ROI calculations include new patient acquisition costs, lifetime patient value, and community engagement metrics. Successful local marketing campaigns generate new patient acquisition at costs 45% lower than digital advertising alone.
Compliance and Best Practices

Healthcare marketing compliance represents a complex intersection of federal regulations, state laws, and industry standards that organizations must navigate while promoting their services. Marketing agencies working with healthcare entities function as business associates under HIPAA, requiring them to perform annual self-audits, conduct employee training programs, and implement comprehensive remediation plans to address compliance gaps.
HIPAA Compliance in Marketing
Protected Health Information (PHI) serves as the cornerstone of HIPAA compliance within healthcare marketing environments. Organizations cannot use or disclose PHI in marketing materials without obtaining prior written patient authorization that details specific information types, intended recipients, authorization expiration dates, and patients' rights to revoke consent at any time.
Marketing strategies that avoid PHI dependency prove more sustainable and legally sound for healthcare organizations. Educational content focusing on general health topics, disease prevention strategies, and wellness advice allows marketers to engage audiences without accessing protected patient data. This approach eliminates authorization requirements while maintaining educational value for potential patients seeking health information.
Email marketing campaigns within healthcare environments require HIPAA-compliant platforms that implement end-to-end encryption, secure data transmission protocols, and documented consent mechanisms. Healthcare organizations utilizing email marketing report 23% higher engagement rates when combining educational content with personalized messaging that doesn't rely on specific patient information.
Social media marketing practices must focus on general wellness advice rather than patient-specific information or treatment outcomes. Healthcare organizations can share health tips, seasonal wellness reminders, community health initiatives, and educational resources without violating HIPAA provisions. Platforms like Facebook and LinkedIn allow healthcare providers to build community engagement through health awareness campaigns that comply with privacy regulations.
Patient testimonials and case studies require explicit written authorization from patients before publication. Authorization documents must specify the exact information disclosed, marketing channels where testimonials will appear, and duration of consent validity. Healthcare organizations implementing structured testimonial programs with proper authorization processes see 31% higher conversion rates while maintaining full HIPAA compliance.
Digital marketing compliance extends to website analytics, social media tracking, and advertising pixel implementations. Healthcare websites must implement HIPAA-compliant analytics tools that encrypt user data, provide opt-out mechanisms, and maintain audit trails for data access. Organizations using compliant analytics platforms demonstrate 18% better patient trust scores compared to those with standard tracking implementations.
Content marketing strategies focusing on educational materials, health condition overviews, and treatment option explanations provide value without requiring PHI access. Healthcare organizations producing 16 or more educational content pieces monthly generate 47% more qualified leads than those publishing fewer educational resources. This content-first approach builds trust while maintaining regulatory compliance across all marketing channels.
Marketing automation within healthcare environments requires platforms that support HIPAA business associate agreements, encrypt all patient communications, and provide granular permission controls. Automated email sequences for appointment reminders, health screenings, and wellness check-ins must obtain explicit patient consent before implementation. Organizations with compliant automation systems report 28% higher appointment attendance rates.
Regulatory Considerations
State privacy laws often impose stricter requirements than federal HIPAA regulations, creating complex compliance environments for multi-state healthcare organizations. California's Consumer Privacy Act requires opt-in consent for promotional communications, while Texas Medical Records Privacy Act mandates specific disclosure statements for marketing materials using patient information.
Multi-state healthcare organizations must adhere to the most restrictive regulations applicable across all operational territories. Organizations operating in five or more states typically maintain 34% higher compliance costs but experience 22% fewer regulatory violations compared to single-state entities. This comprehensive approach prevents costly violations and maintains consistent patient privacy protection across all markets.
FDA regulations govern advertising and promotion of prescription medications, over-the-counter drugs, medical devices, and biological products. Healthcare marketers must provide accurate risk and benefit information in consumer-targeted materials. Pharmaceutical marketing campaigns require FDA review for prescription drug advertisements, with average review periods extending 60-90 days for complex therapeutic areas.
The False Claims Act prohibits submission of fraudulent claims and extends to marketing materials that could influence healthcare utilization patterns. Healthcare organizations must ensure marketing communications don't encourage unnecessary procedures, exaggerate treatment effectiveness, or misrepresent insurance coverage options. Violations can result in penalties ranging from $11,000 to $22,000 per false claim.
CAN-SPAM Act compliance applies to all healthcare email communications, requiring clear sender identification, truthful subject lines, and functional unsubscribe mechanisms. Healthcare organizations must process unsubscribe requests within 10 business days and maintain suppression lists to prevent future communications. Organizations with robust CAN-SPAM compliance report 15% lower spam complaint rates.
General Data Protection Regulation (GDPR) affects healthcare organizations treating European Union residents or maintaining European operations. GDPR requires explicit consent for data processing, provides patients with data portability rights, and mandates breach notifications within 72 hours. Healthcare organizations serving international patients maintain separate consent mechanisms and data processing protocols for GDPR compliance.
State medical board regulations govern healthcare advertising and marketing practices, with requirements varying significantly across jurisdictions. Medical boards may restrict advertising language, require specific disclaimers, or prohibit certain promotional tactics. Organizations operating across multiple states maintain compliance matrices tracking state-specific requirements and update marketing materials accordingly.
Telemedicine marketing faces additional regulatory complexity as virtual care regulations evolve rapidly across states. Organizations promoting telemedicine services must comply with state licensing requirements, patient consent protocols, and technology security standards. Telemedicine providers report 42% more complex compliance requirements compared to traditional healthcare marketing.
Business associate agreements (BAAs) represent critical compliance documents for healthcare marketing relationships. Marketing agencies, advertising platforms, analytics providers, and technology vendors require BAAs when handling PHI or supporting healthcare marketing activities. Organizations maintaining comprehensive BAA programs experience 26% fewer compliance incidents.
Data breach notification requirements mandate specific response protocols when patient information becomes compromised. Healthcare organizations must notify affected patients, regulatory authorities, and business associates within prescribed timeframes. Breach response costs average $10.93 million for healthcare organizations, making prevention through compliance frameworks essential for financial sustainability.
Compliance documentation requirements extend beyond initial policy creation to ongoing monitoring, training, and audit activities. Healthcare organizations must maintain compliance training records, policy acknowledgment documentation, and incident response logs. Regular compliance audits identify gaps before regulatory reviews, reducing violation risks by 35% compared to organizations with ad-hoc compliance approaches.
Technology platforms supporting healthcare marketing must meet specific security and compliance standards including encryption protocols, access controls, and audit logging capabilities. Cloud-based marketing platforms serving healthcare clients require HIPAA compliance certifications, penetration testing reports, and security framework documentation. Organizations using certified compliant platforms report 29% fewer security incidents.
Staff training programs covering HIPAA regulations, state privacy laws, and industry compliance requirements require regular updates and competency assessments. Healthcare marketing teams receiving quarterly compliance training demonstrate 24% higher compliance test scores and generate 19% fewer regulatory inquiries compared to teams with annual training programs.
Compliance monitoring systems track marketing communications, patient interactions, and data access patterns to identify potential violations before they escalate. Automated monitoring platforms flag suspicious activities, unauthorized data access, and policy violations for immediate investigation. Organizations with active monitoring systems reduce compliance violations by 41% compared to those relying on periodic manual reviews.
International compliance considerations affect healthcare organizations with global operations or international patient populations. Organizations must navigate varying privacy laws, advertising regulations, and healthcare marketing restrictions across different jurisdictions. Multi-national healthcare organizations maintain dedicated compliance teams to address jurisdiction-specific requirements.
Vendor compliance management ensures third-party marketing partners, technology providers, and service contractors meet healthcare compliance standards. Organizations must conduct vendor risk assessments, review compliance certifications, and monitor ongoing compliance performance. Comprehensive vendor management programs reduce third-party compliance risks by 38% compared to organizations with limited vendor oversight.
Measuring and Optimizing Performance
Healthcare marketing success hinges on systematic measurement and data-driven optimization strategies that transform campaign insights into actionable improvements. The ability to track, analyze, and refine marketing efforts determines whether organizations achieve their patient acquisition goals while maintaining regulatory compliance.
Analytics and Performance Tracking
Healthcare marketers track patient acquisition cost as their primary financial metric, calculating total marketing spend divided by new patients acquired. Organizations typically report PAC ranging from $150 to $800 per patient, with specialty practices often experiencing higher costs due to targeted demographics and extended decision-making cycles. This metric reveals cost-effectiveness across different marketing channels and helps allocate budgets toward the most productive investments.
Conversion rates provide critical insights into campaign performance, measuring the percentage of visitors who complete desired actions such as appointment scheduling, prescription refills, or treatment inquiries. Healthcare websites typically achieve conversion rates between 2% and 5%, though specialized practices focusing on elective procedures often see rates exceeding 8% when targeting pre-qualified audiences. Email campaigns generate conversion rates averaging 15% to 25% for appointment reminders and health education content.
Patient lifetime value calculation extends beyond initial visits to estimate total revenue generated throughout the patient relationship. Healthcare organizations report LTV ranging from $1,200 for primary care patients to $15,000 for specialty practice patients, with chronic condition management producing the highest values. LTV analysis guides marketing investment decisions by identifying which patient segments generate the most long-term value.
Ready to Grow Your Business?
Get a custom strategy tailored to your goals.
Traffic metrics encompass organic search growth, direct website visits, and referral sources that drive patient engagement. Healthcare websites experiencing consistent growth typically see 10% to 20% monthly increases in organic traffic when implementing comprehensive SEO strategies. Click-to-call rates from mobile devices average 4% to 6% for healthcare organizations, with emergency services and urgent care facilities achieving rates above 12%.
Video engagement metrics reveal content effectiveness across patient education materials and promotional content. Healthcare videos achieve average watch times of 45 to 90 seconds, with patient testimonials and procedure explanations generating the highest completion rates. Organizations track engagement duration, replay rates, and social sharing to optimize content creation strategies.
Appointment show rates directly impact revenue and operational efficiency, with healthcare organizations monitoring no-show percentages averaging 15% to 25% across different specialties. Practices implementing automated reminder systems and patient engagement technologies reduce no-show rates by 30% to 40%, creating measurable improvements in practice productivity and patient satisfaction scores.
Call tracking systems assign unique phone numbers to different marketing channels, enabling precise attribution of patient inquiries to specific campaigns. Healthcare organizations using call tracking report attribution accuracy improvements of 65% to 80%, allowing marketers to identify which channels generate the highest-quality leads and optimize spending accordingly.
Search engine ranking analysis monitors visibility for targeted keywords related to medical conditions, treatments, and practice locations. Healthcare organizations track rankings for 50 to 200 keywords, with successful SEO campaigns achieving first-page rankings for 40% to 60% of targeted terms within 6 to 12 months.
Social media analytics measure engagement rates, follower growth, and content performance across platforms where healthcare organizations maintain presence. Facebook posts from healthcare providers achieve engagement rates averaging 3% to 6%, while educational content and community health initiatives generate significantly higher interaction levels.
Patient feedback metrics from surveys and online reviews provide qualitative insights into marketing message effectiveness and brand perception. Healthcare organizations monitoring online reputation report that practices maintaining 4.5-star ratings or higher experience 25% to 35% more new patient inquiries compared to those with lower ratings.
Continuous Improvement Strategies
Segmentation and cohort analysis enable healthcare marketers to identify distinct patient groups based on demographics, medical conditions, and behavioral patterns. Organizations implementing advanced segmentation strategies report 40% to 60% improvements in campaign relevance and patient response rates. Cohort analysis reveals how different patient groups interact with marketing messages over time, enabling refinement of targeting strategies and content personalization.
Healthcare marketers segment audiences by treatment categories, insurance types, geographic locations, and engagement histories to create more effective messaging strategies. Practices serving diverse populations often develop 8 to 12 distinct patient personas, each requiring tailored communication approaches and channel strategies.
A/B testing protocols allow healthcare organizations to experiment with different messaging approaches, visual designs, and communication channels while maintaining compliance standards. Email subject line testing typically reveals 15% to 25% variations in open rates between different approaches, while landing page design experiments generate conversion rate improvements of 20% to 40%.
Multivariate testing expands beyond simple A/B comparisons to examine multiple variables simultaneously, providing deeper insights into optimal campaign configurations. Healthcare organizations conducting multivariate tests on appointment booking pages report conversion improvements ranging from 35% to 55% when optimizing form fields, trust signals, and call-to-action placement together.
Testing protocols must account for longer healthcare decision-making cycles, with most experiments requiring 4 to 8 weeks of data collection to achieve statistical significance. Organizations track confidence levels above 95% before implementing winning variations across broader campaigns.
Incrementality testing measures the true impact of marketing campaigns by comparing results against control groups that don't receive marketing exposure. Healthcare organizations using incrementality testing discover that 20% to 30% of attributed conversions would have occurred without marketing intervention, leading to more accurate ROI calculations and budget allocation decisions.
Brand lift studies assess changes in brand awareness, perception, and consideration following marketing campaigns. Healthcare organizations conducting brand lift studies report awareness increases ranging from 8% to 25% following integrated marketing campaigns, with video content and community outreach generating the strongest brand recognition improvements.
Patient journey mapping combines analytics data with behavioral insights to identify optimization opportunities throughout the healthcare experience. Organizations mapping complete patient journeys discover 3 to 5 critical touchpoints where improved messaging or process refinements significantly impact conversion rates and patient satisfaction.
Marketing attribution modeling helps healthcare organizations understand which touchpoints contribute most effectively to patient acquisition. Multi-touch attribution reveals that patients typically interact with 6 to 8 marketing touchpoints before scheduling appointments, emphasizing the importance of coordinated messaging across channels.
Performance benchmarking against industry standards provides context for marketing results and identifies improvement opportunities. Healthcare organizations comparing their metrics against peer benchmarks often discover 15% to 30% performance gaps in specific areas, leading to targeted improvement initiatives.
Data integration strategies combine marketing metrics with clinical outcomes and patient satisfaction scores to measure comprehensive campaign effectiveness. Organizations implementing integrated measurement systems report clearer connections between marketing investments and overall practice performance, enabling more strategic resource allocation decisions.
Predictive analytics models forecast patient behavior and campaign performance based on historical data patterns. Healthcare organizations using predictive modeling achieve 25% to 40% improvements in campaign targeting accuracy, reducing waste while improving patient acquisition efficiency.
Real-time optimization platforms enable immediate campaign adjustments based on performance data, allowing healthcare marketers to respond quickly to changing patient needs and market conditions. Organizations implementing real-time optimization report 20% to 35% improvements in campaign efficiency through continuous adjustment processes.
Compliance monitoring systems ensure that performance optimization efforts maintain adherence to HIPAA requirements and other healthcare regulations. Automated compliance checking prevents data usage violations while enabling comprehensive performance analysis within legal boundaries.
Quality scoring systems evaluate marketing content and campaigns against medical accuracy standards and regulatory requirements. Healthcare organizations implementing quality scoring report 45% to 60% reductions in compliance-related content revisions, streamlining campaign development processes.
Cross-channel performance analysis reveals how different marketing channels work together to influence patient decisions. Healthcare organizations analyzing cross-channel attribution discover that social media exposure increases email engagement rates by 30% to 45%, while SEO content consumption improves PPC campaign conversion rates by 20% to 35%.
Patient retention analysis tracks how marketing efforts influence long-term patient relationships and repeat visit patterns. Organizations focusing on retention metrics report that patients acquired through educational content marketing demonstrate 25% to 40% higher lifetime values compared to those acquired through promotional campaigns.

Conclusion
Healthcare organizations that master the art of strategic marketing while maintaining ethical standards position themselves for sustainable growth in an increasingly competitive landscape. The integration of digital technologies with patient-centered approaches creates opportunities to reach and engage audiences more effectively than ever before.
Success in healthcare marketing requires a delicate balance between promotional objectives and regulatory compliance. Organizations that prioritize transparency trust-building and authentic patient relationships consistently outperform those focused solely on traditional sales metrics.
The future belongs to healthcare marketers who embrace data-driven strategies while never losing sight of their primary mission: improving patient outcomes and community health. By combining innovative digital tools with genuine care for patient wellbeing organizations can achieve both business growth and meaningful impact in the communities they serve.
References:
American Medical Association. (2024). Digital Health Study: Patients and Technology 2024. AMA Publications.
Healthcare Financial Management Association. (2024). Healthcare Marketing ROI Benchmarks and Best Practices. HFMA Research.
Medical Marketing Association. (2025). State of Healthcare Marketing Report: Digital Transformation and Patient Engagement Trends.
Pew Research Center. (2024). Health Information and Digital Health Tools Usage Among U.S. Adults.
Press Ganey Associates. (2024). Patient Experience and Healthcare Marketing Effectiveness Study.
U.S. Department of Health and Human Services. (2024). HIPAA Compliance Guidelines for Healthcare Marketing Communications.
American Hospital Association. "Healthcare Marketing Trends and Best Practices Report." Healthcare Financial Management, 2024.
Centers for Disease Control and Prevention. "Digital Health Communication Guidelines for Healthcare Organizations." Public Health Reports, 2025.
Healthcare Financial Management Association. "Marketing ROI Benchmarks in Healthcare." HFMA Research, 2024.
Journal of Healthcare Marketing. "Patient Persona Development and Segmentation Strategies." Healthcare Marketing Research, 2025.
Medical Marketing & Media. "Healthcare Consumer Behavior Analysis." Industry Research Report, 2024.
National Association for Healthcare Quality. "Patient Experience and Marketing Alignment." Quality Management Journal, 2025.
Digital Health Trends Report, Healthcare Marketing Association, 2025
AI in Healthcare Marketing Study, Medical Technology Research Institute, 2024
Patient Digital Behavior Analysis, Healthcare Consumer Insights, 2024
SEO Performance in Healthcare Study, Digital Marketing Healthcare Council, 2024
PPC Advertising Effectiveness in Medical Services, Healthcare Advertising Analytics, 2025
Healthcare Financial Management Association. (2024). Digital Marketing Strategies for Healthcare Organizations: A Comprehensive Guide.
American Medical Association. (2024). Social Media Guidelines for Healthcare Professionals.
Medical Marketing Research Institute. (2025). Patient Review Behavior and Healthcare Decision Making Study.
Healthcare Marketing Association. (2024). Referral Program Effectiveness in Medical Practices.
Digital Health Marketing Council. (2024). HIPAA Compliance in Healthcare Social Media Marketing.
Patient Experience Research Foundation. (2025). Online Reputation Management Impact on Healthcare Organizations.
Medical Practice Management Journal. (2024). ROI Analysis of Healthcare Referral Programs.
Healthcare Social Media Association. (2024). Platform-Specific Marketing Strategies for Medical Practices.
Patient Engagement Institute. (2025). The Role of Social Media in Healthcare Patient Education.
American Hospital Association. (2024). Regulatory Compliance in Healthcare Digital Marketing.
American Hospital Association. (2024). Healthcare Marketing Trends and Patient Engagement Strategies. Hospital Marketing Report, 18(3), 23-31.
Digital Health Marketing Institute. (2025). Video Content Performance in Healthcare Settings. Journal of Healthcare Digital Marketing, 7(2), 45-52.
Healthcare Communications Research Group. (2024). Email Marketing Effectiveness in Patient Care Coordination. Medical Marketing Quarterly, 29(4), 78-85.
Institute for Healthcare Marketing Analytics. (2025). Local SEO Impact on Healthcare Patient Acquisition. Healthcare Marketing Science, 12(1), 34-42.
National Healthcare Marketing Association. (2024). Community Outreach ROI Analysis for Healthcare Organizations. Healthcare Business Review, 41(6), 67-73.
Patient Experience Research Council. (2025). Video Testimonials and Healthcare Decision Making. Patient Choice Studies, 15(2), 89-96.
Healthcare Digital Strategy Foundation. (2024). AI Integration in Healthcare Marketing Communications. Medical Technology Marketing, 8(4), 112-119.
American Medical Marketing Association. (2025). HIPAA Compliance in Digital Healthcare Marketing. Healthcare Legal Marketing, 22(1), 203-211.
Community Health Marketing Institute. (2024). Local Partnership Strategies for Healthcare Organizations. Regional Healthcare Marketing, 19(3), 156-164.
Healthcare Video Marketing Alliance. (2025). Patient Education Video Effectiveness Metrics. Medical Education Marketing, 11(2), 91-98.
Healthcare Information and Management Systems Society. "HIPAA Compliance in Digital Marketing." 2024.
American Hospital Association. "Multi-State Healthcare Compliance Framework." 2024.
U.S. Department of Health and Human Services. "HIPAA Business Associate Agreements Guide." 2024.
Healthcare Financial Management Association. "State Privacy Law Compliance Matrix." 2024.
Medical Marketing Association. "Digital Healthcare Marketing Compliance Study." 2024.
Healthcare Data Breach Report. "Annual Healthcare Security Analysis." 2024.
National Association of Healthcare Marketing Directors. "Compliance Training Effectiveness Research." 2024.
Healthcare Technology Compliance Institute. "Platform Security Certification Standards." 2024.
American Medical Association. (2024). Healthcare Marketing Guidelines and Best Practices. AMA Publishing.
Healthcare Financial Management Association. (2024). Patient Acquisition Cost Benchmarking Study. HFMA Research.
Medical Marketing Association. (2025). Digital Healthcare Marketing Performance Report. MMA Analytics.
Journal of Healthcare Marketing. (2024). Patient Journey Analytics and Attribution Modeling. Healthcare Marketing Research Quarterly.
Healthcare Marketing Institute. (2024). Conversion Rate Optimization in Healthcare Settings. HMI Publications.
American Hospital Association. (2024). Patient Engagement and Marketing ROI Analysis. AHA Healthcare Research.
Digital Health Analytics. (2025). Healthcare Video Marketing Performance Metrics. DHA Industry Report.
Patient Experience Journal. (2024). Online Reputation Management and Patient Acquisition. PEJ Research Division.
Healthcare Business Review. (2024). Marketing Attribution and Performance Measurement. HBR Healthcare Analytics.
Modern Healthcare Marketing. (2025). Predictive Analytics in Healthcare Marketing. MHM Research Institute.
Written by Cristina Arcega-Punzalan
Cristina Arcega-Punzalan is a content writer at AMW®, covering topics in marketing, entertainment, and brand strategy.
Ready to Grow Your Business?
Get a custom strategy tailored to your goals.
Frequently Asked Questions
How does healthcare marketing differ from traditional marketing strategies?
Healthcare marketing operates under strict regulatory frameworks including HIPAA compliance and FDA guidelines that govern medical claims and patient privacy. Unlike traditional marketing focused on sales, healthcare marketing prioritizes patient trust, ethical communication, and clinical accuracy. Healthcare marketers must balance promotional goals with patient wellbeing, avoid making unsubstantiated medical claims, and ensure all communications maintain transparency while adhering to professional medical standards and regulatory requirements.
What are the most effective digital marketing strategies for healthcare providers?
Effective healthcare digital marketing combines local SEO optimization, educational content marketing, and compliant social media engagement. Key strategies include optimizing Google Business Profiles for local searches, creating authoritative content that answers patient questions, implementing targeted email campaigns for appointment reminders and health education, and utilizing video content to explain procedures. These approaches must maintain HIPAA compliance while building trust through transparent, accurate medical information.
How can healthcare organizations build patient trust through marketing?
Healthcare organizations build patient trust by maintaining consistent, transparent messaging across all channels, sharing verified patient testimonials and clinical outcomes data, demonstrating community involvement, and providing accurate, evidence-based health information. Trust-building strategies include showcasing professional credentials, publishing quality metrics, responding promptly to patient inquiries, and ensuring all marketing communications prioritize patient education over promotional content while maintaining empathetic, accessible communication tone.
What HIPAA compliance requirements affect healthcare marketing campaigns?
HIPAA compliance in healthcare marketing requires strict patient data protection protocols, obtaining proper consent before using patient information, and ensuring secure handling of all personal health data. Marketing teams must implement data encryption, limit access to patient information, avoid sharing identifiable patient details without consent, and maintain audit trails for all data usage. Email marketing platforms and analytics tools must be HIPAA-compliant to protect patient privacy throughout marketing activities.
How do healthcare providers optimize for local search and patient acquisition?
Healthcare local search optimization involves claiming and optimizing Google Business Profile listings with accurate NAP information, collecting and responding to patient reviews, creating location-specific content addressing community health needs, and maintaining consistent directory listings across multiple platforms. Providers should focus on location-based keywords, publish community health resources, participate in local health events, and ensure mobile-optimized websites with clear contact information and appointment scheduling capabilities.
What types of content marketing work best for healthcare organizations?
Effective healthcare content marketing includes educational blog posts addressing common health concerns, video content explaining procedures and treatments, downloadable health guides and symptom checkers, patient success stories, and preventive care resources. Content should focus on answering patient questions, providing evidence-based health information, explaining complex medical topics in accessible language, and demonstrating clinical expertise while maintaining accuracy and avoiding direct medical advice that requires professional consultation.
How should healthcare organizations measure marketing ROI and patient acquisition costs?
Healthcare marketing ROI measurement involves tracking patient acquisition costs, appointment conversion rates, patient lifetime value, and quality metrics beyond simple revenue figures. Key performance indicators include cost per lead, appointment show rates, patient retention rates, online review scores, and website conversion metrics. Healthcare organizations should implement call tracking, use HIPAA-compliant analytics tools, monitor referral sources, and measure long-term patient relationships rather than focusing solely on immediate conversions.
Related Resources
Calculators
Pricing Guides
Key Terms
Optimization of individual web page elements including content, HTML source code, and meta tags to rank higher in search results.
Keyword DifficultyA metric estimating how hard it would be to rank on the first page of search results for a specific keyword.
Content DecayThe gradual decline in organic traffic and rankings that content experiences over time as it becomes outdated or outranked.
Brand SalienceThe degree to which your brand comes to mind quickly and easily when customers think about your product category.
Answer Engine OptimizationOptimizing content for AI answer engines and conversational search interfaces.
Related Articles
50 Medical PR Strategies That Transform Healthcare Communication and Build Trust
Healthcare organizations encounter unique communication challenges that require specialized expertise in medical PR. These professionals bridge complex medical information with public...
Proven Media Relations Strategies That Will Transform Your Brand's Public Image
Effective media relations strategies are crucial for successful public relations campaigns, enabling organizations to build strong relationships with journalists and enhance brand visibility....
The Ultimate Guide to Mastering Online Marketing in 2026
Online marketing stands as a pivotal element for business growth and customer engagement. Unlike traditional marketing methods like print ads, online marketing leverages the digital world's expans